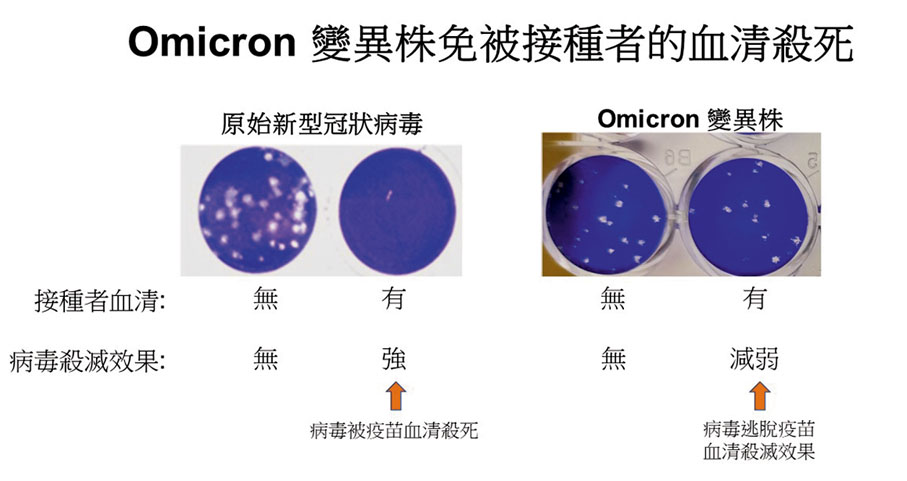
●港大和中大聯合研究表明，Omicron可大幅減低復必泰疫苗的病毒中和能力。

復必泰對付奧毒「不給力」 專家:防死亡重症仍有效
香港文匯報訊(記者 文森)香港昨日新增5宗新冠肺炎輸入個案,當中兩名由英國返港的男女均帶有N501Y變異病毒株,有機會是感染新型變種毒病Omicron(奧密克戎),而該病毒已擴散至全球逾70國家地區。香港中文大學和香港大學昨日公布首項針對Omicron的聯合研究,指出該病毒令復必泰疫苗的中和抗體水平下降97%,研究團隊相信科興疫苗亦對Omicron喪失很多保護力。不過,專家表示疫苗對預防死亡及重症仍然有效,預期本港稍後也需要全民接種第三劑疫苗。
昨增5宗輸入個案
香港昨日新增個案涉及兩男3女,當中一名62歲男患者及另一名50歲女患者已先後在本港接種兩劑復必泰疫苗,而兩人本月10日搭乘國泰航空CX252航班由英國回港,結果在機場檢測呈陽性,並發現有N501Y變異病毒株,由於目前正在全球蔓延的Omicron變種病毒也有N501Y變異,而英國的病例亦暴增,故兩人可能亦感染該病毒,倘進一步檢測證實屬有關病毒,將令本港的Omicron個案增至7宗。
至於另三宗個案,當中兩名女患者為菲律賓抵港的外傭,她們已在菲國接種疫苗,分別在竹篙灣檢疫中心及青衣華逸酒店檢疫期間確診,當中一人帶有L452R變異病毒株,另一人病毒量不足未能確診是否感染變種病毒;餘下一名14歲男患者則在本港接種了一劑復必泰疫苗,本月5日由英國返港,檢疫期間確診並有L452R變異病毒株。
另外,港大及中大醫學院研究團隊則利用10名已接種兩劑復必泰疫苗人士的血液,測試對原始新冠病毒及Omicron病毒的反應。血液樣本是在第二劑疫苗注射後約一個月內採集,當時抗體水平應最高,結果發現大部分人殺滅原始新冠病毒的能力也很高,抗體達320個單位,但殺滅Omicron的能力卻大減,僅約10個單位。團隊成員的港大公共衞生學院病毒學講座教授裴偉士表示,研究反映疫苗對付Omicron時,其保護力顯著下降。
許樹昌:打第三針勢在必行
參與研究的中大醫學院內科及藥物治療學系系主任許樹昌指出,這意味打兩針復必泰產生的抗體對Omicron幾乎無效,但這只是研究針對病毒表面刺突蛋白的免疫反應,輝瑞藥廠最新試驗數據,打第三針復必泰後抗體升25倍,而南非的部分初步數據亦顯示打三針復必泰對Omicron的保護率仍有75%,疫苗能預防死亡及重症,呼籲所有合資格人士及早完成接種,打第三針更是勢在必行。他表示,衞生署轄下的科學委員會本月23日開會,預計將討論擴展接種第三劑復必泰的安排。
另一方面,香港特區政府昨晚宣布,由於毛里求斯及塞拉利昂確認發現Omicron個案,特區政府會將該兩個地區列為A組高風險地區,本周三(15日)凌晨零時生效,非香港居民不准入境,香港居民須完成接種疫苗並接受21天強制檢疫。
